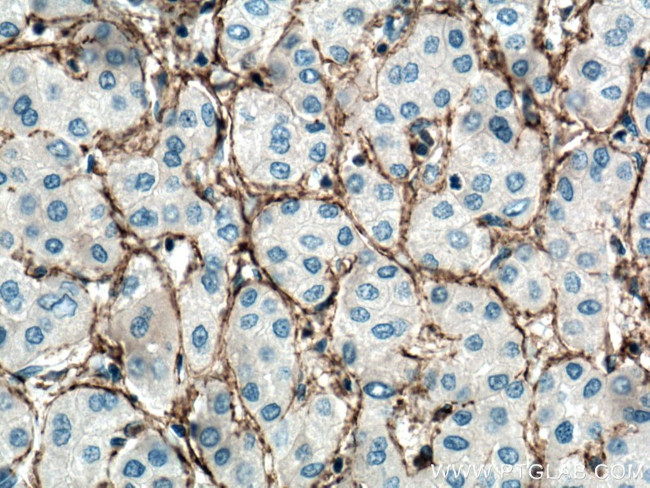
CXCR3B Antibody in Immunohistochemistry (Paraffin) (IHC (P))

Search
Proteintech
CXCR3B Monoclonal Antibody (1B2D6)
{{$productOrderCtrl.translations['antibody.pdp.commerceCard.promotion.promotions']}}
{{$productOrderCtrl.translations['antibody.pdp.commerceCard.promotion.viewpromo']}}
{{$productOrderCtrl.translations['antibody.pdp.commerceCard.promotion.promocode']}}: {{promo.promoCode}} {{promo.promoTitle}} {{promo.promoDescription}}. {{$productOrderCtrl.translations['antibody.pdp.commerceCard.promotion.learnmore']}}
产品信息
60065-1-IG
种属反应
已发表种属
宿主/亚型
分类
类型
克隆号
抗原
偶联物
形式
浓度
规格
纯化类型
保存液
内含物
保存条件
运输条件
产品详细信息
This monoclonal antibody is specific to CXCR3B.
靶标信息
Chemokines play important roles in inflammation and critical for the recruitment of effector immune cells to sites of infection. Historically, CD183 was the third CXC chemokine receptor discovered and therefore, commonly designated as CXCR3. Binding of chemokines to CD183 induces cellular responses that are involved in leukocyte traffic, most notably integrin activation, cytoskeletal changes and chemotactic migration. The CXC chemokine receptor (CXCR) 3, a G-protein-coupled 7-transmembrane receptor, is expressed at high levels on activated and memory T cells, B cells, natural killer cells, and plasmacytoid monocytes.
仅用于科研。不用于诊断过程。未经明确授权不得转售。
生物信息学
蛋白别名: C-X-C chemokine receptor type 3; CD183; chemokine (C-X-C motif) receptor 3; chemokine (C-X-C motif) receptor 3 isoform CXCR3_1; chemokine (C-X-C motif) receptor 3 isoform CXCR3_2; chemokine receptor 3; CKR-L2; CXC-R3; CXCR3-B; G protein-coupled receptor; G protein-coupled receptor; G protein-coupled receptor 9; Interferon-inducible protein 10 receptor; IP-10 receptor; Mig receptor; unnamed protein product
基因别名: CD182; CD183; CKR-L2; CMKAR3; CXCR3; GPR9; IP10-R; Mig-R; MigR
UniProt ID: (Human) P49682
Entrez Gene ID: (Human) 2833